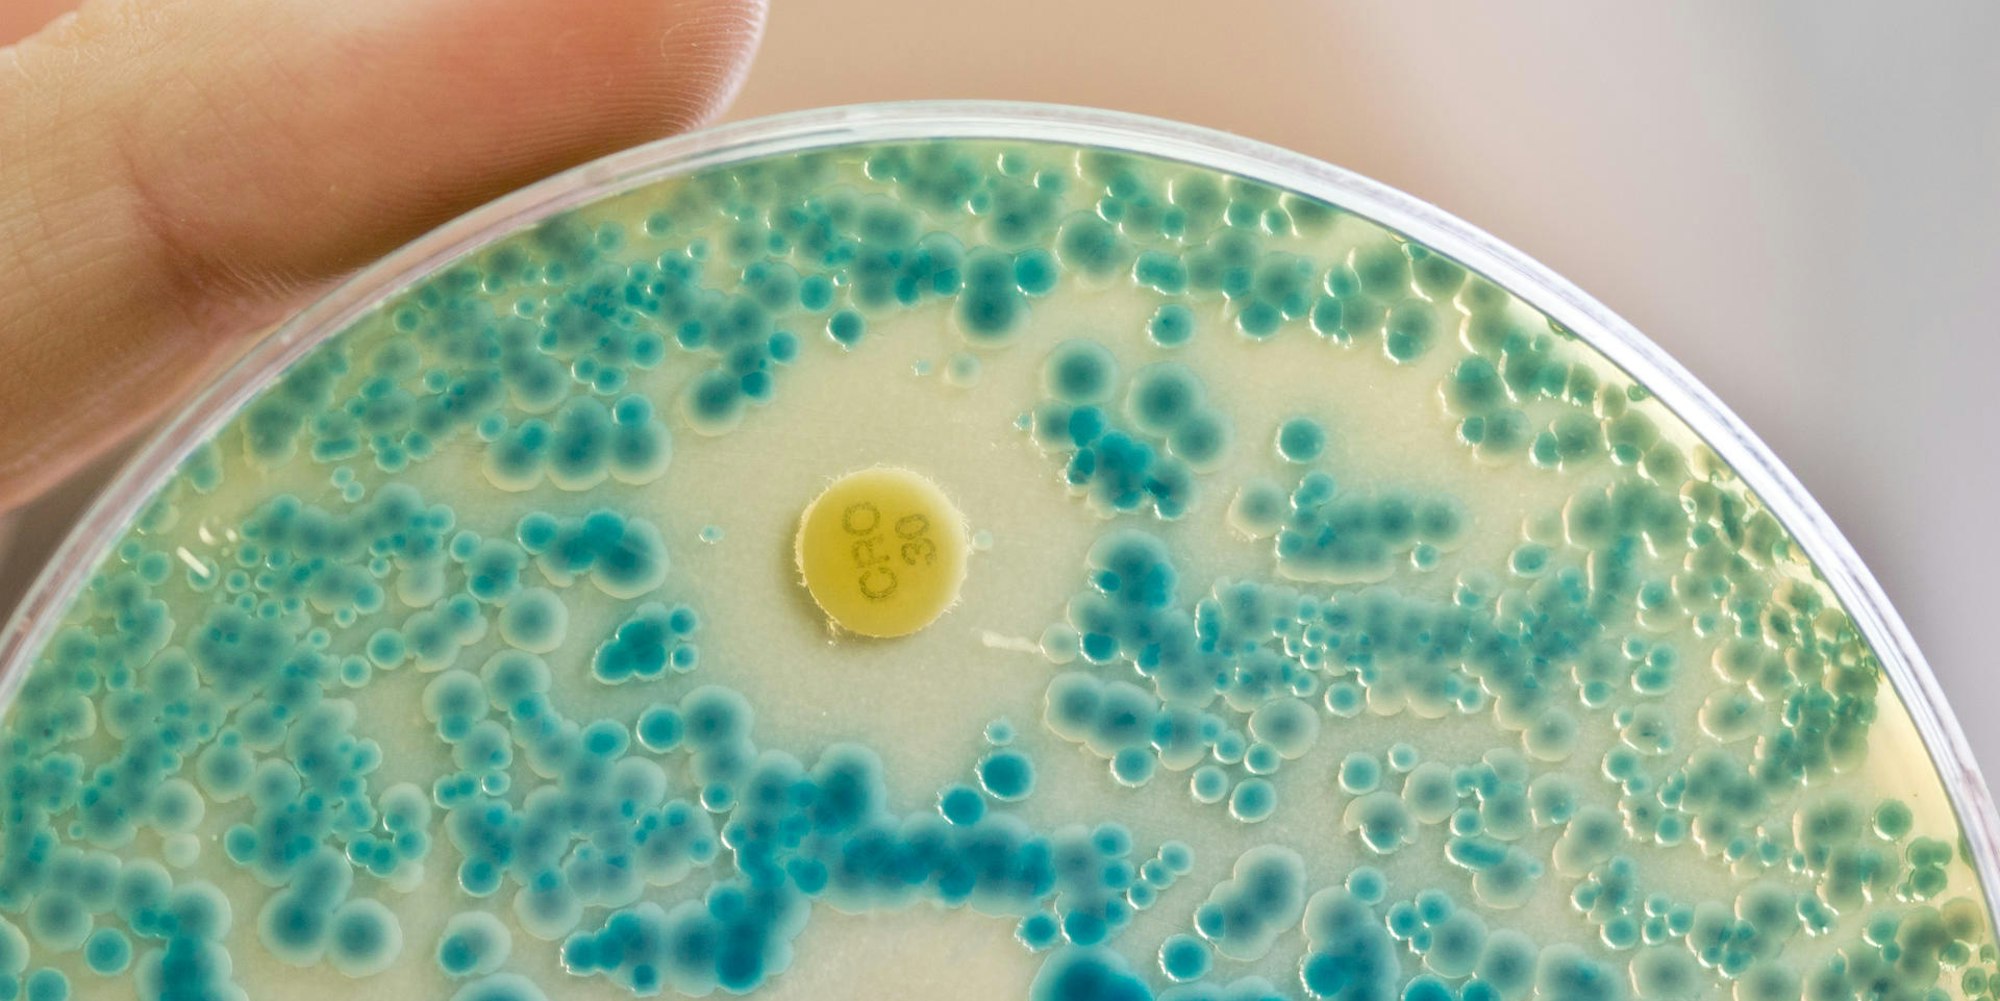
Bakterien

SchutzpolizeiIntaktes Immunsystem ist das beste Mittel gegen Viren und Bakterien
Aus dem Diagnostiklabor: Eine Indikatorkulturplatte zum Nachweis von resistenten Bakterien.
Copyright: dpa
Köln – Ohne Bakterien geht es nicht. Wir brauchen sie zum Leben. Hauptsache sie sind vielfältig - vor allem im Darm. Die Bakterien-Zusammensetzung in diesem viele Meter langen Organ sollte einem Mischwald entsprechen: von jedem etwas und im richtigen Verhältnis. Wer der Auffassung ist, dass diese gesunde Mixtur durch den Genuss probiotischer Joghurtsorten und ähnlicher Produkte noch zusätzlich positiv beeinflusst wird, darf ruhig weiterhin daran glauben - wissenschaftlich bewiesen ist es nicht. Aber es schadet ja nicht, diese Joghurts zu löffeln. Das macht vielleicht nicht den Darm, dafür aber einen Industriezweig glücklich. Ebenso verhält es sich mit den Versprechungen, bestimmte freiverkäufliche Mittel bauten die Darmflora nach einer Antibiotika-Therapie wieder auf. "Es gibt keine wissenschaftlichen Beweise", so Professor Gerd Fätkenheuer, Leiter der Infektiologie an der Uniklinik Köln und Präsident der Deutschen Gesellschaft für Infektiologie.
Bakterien in Lauerstellung
Wer von der Wohltat der Bakterien im Darm überzeugt ist, sie aber außerhalb des Darms nicht sonderlich gern mag und seine Wohnung, speziell die Toilette, antibakteriell sauber schrubbt, darf das weiterhin tun. Aber für Bakterien gilt: ...und wenn sie nicht gestorben sind, dann leben sie noch heute. Mehr noch. Gerd Fätkenheuer: "Das, was man nicht sieht, ist gefährlich. Der Schmutz auf der Toilette ist hässlich und eklig, aber in der Regel nicht sonderlich gefährlich." Die große Angst vor Viren und Bakterien ist häufig übertrieben. Ausnahme: Cholera-, Typhus und andere Darmbakterien. Sie breiten sich aufgrund prekärer Hygiene-Verhältnisse aus, was in unseren Breiten aber praktisch nicht vorkommt.
In der Regel leben Abermilliarden Bakterien in und auf unserem Körper und schaden uns nicht. Es sei denn, das Immunsystem ist geschwächt und die Bakterien gelangen dorthin, wo sie nicht hingehören. Oder aber, sie haben Abwehrmechanismen entwickelt, vor allem gegen Antibiotika, sodass diese den kranken Menschen nicht mehr gesund machen können.
Bakterien entwickeln Resistenzen
Dass Bakterien Resistenzen, also Abwehrmechanismen, entwickeln, ist ganz normal. Man hat sogar in historischen Funden Bakterien entdeckt, die einige tausend Jahre alt sind, nie ein Antibiotikum gesehen haben und trotzdem Resistenzen hatten. Gerd Fätkenheuer: "Resistente Bakterien bilden sich per Zufall auf natürliche Weise. Sie haben einen Überlebensvorteil, wenn Antibiotika gegeben werden, die nicht-resistente Bakterien abtöten." Sie wachsen und vermehren sich, verdrängen andere Bakterienstämme, verändern das bakterielle Gleichgewicht, können in Wunden oder die Blutbahn eindringen und den Menschen schwer krank machen. Bakterien werden oftmals schon innerhalb weniger Tage resistent. Einmal resistent heißt aber nicht immer resistent. Bakterien können diese Eigenschaft wieder ablegen. Aber schlau wie sie nun mal sind, verharren manche resistente Bakterien in Lauerstellung und treten bei der nächsten Behandlung wieder in Aktion.
Bakterien haben nicht umsonst Jahrmillionen überlebt und gelernt, sich zu wehren. Sie vermehren sich durch Teilung und haben einen eigenen Stoffwechsel. Im Vergleich dazu sind Viren geradezu primitiv, was sie aber nicht weniger gefährlich macht. Fätkenheuer. "Antibiotika helfen hier nicht. Bis vor rund 30 Jahren gab es gar keine Wirkstoffe gegen Viren. Die sind deshalb so schwierig zu entwickeln, weil Viren extrem unterschiedlich und wandelbar sind." Erinnert sei nur an das tödliche Ebola-Virus, das HI-Virus, also Aids, das die Zelle missbraucht und sie zwingt, für die Viren zu arbeiten. Oder aber die hochgefährlichen Grippe-Viren und schwere viralen Entzündungen der Leber, bekannt als Hepatitis B und C. Im Gegensatz zu Bakterien brauchen Viren zum Überleben einen Wirt - seien es Pflanzen, Tiere oder Menschen. Suchen sie sich zum Andocken Abwehrzellen aus, so können sie damit das Immunsystem schädigen. Damit beginnt ein gefährlicher Kreislauf. Der Infektiologe Fätkenheuer: "Infektion bedeutet immer, es kommt etwas von außen und unser Immunsystem hat damit ein Problem." Viren sind so raffiniert, dass manche von ihnen sogar an Bakterien andocken und sich in ihnen vermehren können, indem sie den Stoffwechsel der Bakterie nutzen und diese dadurch abtöten. Diesen Effekt versucht man in der Arzneimittel-Forschung einzusetzen. Fätkenheuer: "Man bemüht sich, für den Menschen unschädliche Viren zu züchten und zu isolieren, die gezielt bestimmte Bakterien schädigen oder abtöten." Vorstellbar ist, dass man solche Viren auf antibiotikaresistente Bakterien ansetzt. Doch das ist Zukunftsmusik.
Zu häufiger Einsatz von Antibiotika
Die Ausbreitung resistenter Bakterien schreibt man vor allem dem zu häufigen Einsatz von Antibiotika zu. Immerhin erfolgen 80 bis 85 Prozent aller Antibiotika-Verordnungen in Arztpraxen. Fätkenheuer: "Aber nicht weil Ärzte dumm oder renitent sind und deshalb freudig Antibiotika verschreiben, sondern weil es oftmals schwierig ist zu erkennen, ob es sich um eine Krankheit handelt, die durch Bakterien oder Viren verursacht wurde." Und es gibt Situationen, da können Ärzte nun mal nicht abwarten, bis die zweifelsfreie Diagnose feststeht. "Wenn jemand schwer krank ist, muss man mit schwerem Geschütz auffahren." Das sind in der Regel Antibiotika.
Unterschiedliche Anzeichen für Infektion
Es gibt ganz unterschiedliche Anzeichen für eine Infektion, gleich welcher Ursache: Fieber, erhöhter Pulsschlag und Blutanalysen mit hohen Entzündungswerten, die bei einer Infektion durch Bakterien oft deutlich höher sind als bei einer Infektion durch Viren. Fätkenheuer: "Röntgen-Aufnahmen und Computertomographien werden zusätzlich gemacht, denn Bilder sind ein wichtiges Hilfsmittel. Aber auch vom Bild allein lässt sich häufig kein Rückschluss darauf ziehen, ob Viren oder Bakterien im Spiel sind." Um das zu beurteilen, braucht man schon ziemlich viel Erfahrung. Damit und mit der Kombination der Beschwerden lässt sich eine konkrete Aussage treffen. Im Zweifelsfall müssen Antibiotika gegeben werden.
Fakt ist, dass Antibiotika nicht nur die "bösen" Bakterien töten, sondern andere Bakterien schädigen und deren Vielfalt mindern. Das tritt schon nach wenigen Tagen nach der Antibiotika-Einnahme auf. Bis sich der Bakterien-Haushalt wieder regeneriert, können Wochen und Monate vergehen. Der Mediziner hat es aber in der Hand, "möglichst schmal und gezielt zu therapieren", so Fätkenheuer, "denn je breiter ich mit Antibiotika behandle, desto größer ist die Gefahr einer Resistenz und unerwünschter Nebenwirkungen." Trotz aller Kritik weiß Fätkenheuer sehr wohl, dass Antibiotika "nach wie vor sehr wertvolle und segensreiche Medikamente sind. Deren Wirkung wollen wir so lange wie möglich erhalten".
Veranstaltung
"Viren, Bakterien, Immunsystem - was uns hilft, was uns schadet" Experte: Prof. Gerd Fätkenheuer. Moderation: Marie-Anne Schlolaut. Donnerstag, 6. April, 19 Uhr, studio dumont, Breite Straße 72, Köln. Einlass: 18 Uhr.
Karten zum Preis von 14 Euro, Abocard 12 Euro - jeweils inkl. VVK-Gebühren - sind ab sofort erhältlich. Abocard-Ticket-Hotline: 0221/28 03 44
